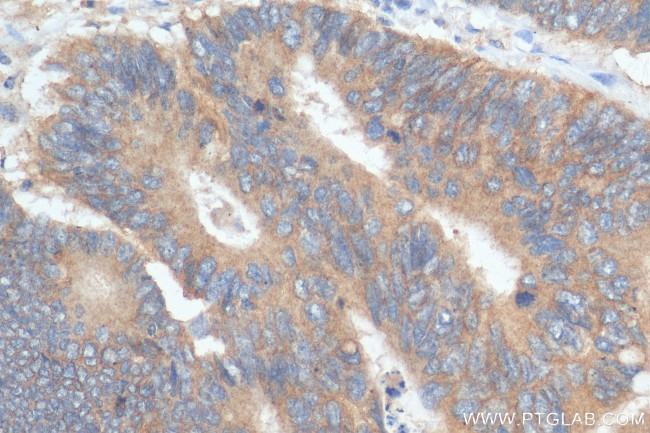
ENT1 Antibody in Immunohistochemistry (Paraffin) (IHC (P))

Search
Proteintech
ENT1 Polyclonal Antibody
{{$productOrderCtrl.translations['antibody.pdp.commerceCard.promotion.promotions']}}
{{$productOrderCtrl.translations['antibody.pdp.commerceCard.promotion.viewpromo']}}
{{$productOrderCtrl.translations['antibody.pdp.commerceCard.promotion.promocode']}}: {{promo.promoCode}} {{promo.promoTitle}} {{promo.promoDescription}}. {{$productOrderCtrl.translations['antibody.pdp.commerceCard.promotion.learnmore']}}
产品信息
29862-1-AP
种属反应
宿主/亚型
分类
类型
抗原
偶联物
形式
纯化类型
保存液
内含物
保存条件
运输条件
产品详细信息
Immunogen sequence: NFFMTATQYF TNRLDMSQNV SLVTAELSKD AQASAAPAAP LPERNSLSAI FNN
靶标信息
This gene is a member of the equilibrative nucleoside transporter family. The gene encodes a transmembrane glycoprotein that localizes to the plasma and mitochondrial membranes and mediates the cellular uptake of nucleosides from the surrounding medium. The protein is categorized as an equilibrative transporter that is sensitive to inhibition by nitrobenzylthioinosine. Nucleoside transporters are required for nucleotide synthesis in cells that lack de novo nucleoside synthesis pathways, and are also necessary for the uptake of cytotoxic nucleosides used for cancer and viral chemotherapies. Multiple alternatively spliced variants, encoding the same protein, have been found for this gene.
仅用于科研。不用于诊断过程。未经明确授权不得转售。
篇参考文献 (0)
生物信息学
蛋白别名: Equilibrative NBMPR-sensitive nucleoside transporter; equilibrative nitrobenzylmercaptopurine riboside (NBMPR)-sensitive nucleoside transporter; Equilibrative nitrobenzylmercaptopurine riboside-sensitive nucleoside transporter; Equilibrative nucleoside transporter 1; equilibrative nucleoside transporter 1 variant delta 11; es nucleoside transporter; HENT1; mENT1; NBMPR-sensitive equilibrative nucleoside transporter; Nucleoside transporter, es-type; solute carrier family 29 (equilibrative nucleoside transporter), member 1; solute carrier family 29 (nucleoside transporters), member 1; Solute carrier family 29 member 1; unnamed protein product
基因别名: 1200014D21Rik; AA407560; AUG; ENT1; hENT1; SLC29A1
UniProt ID: (Human) Q99808, (Mouse) Q9JIM1
Entrez Gene ID: (Human) 2030, (Mouse) 63959